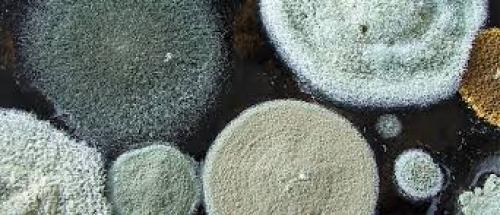
Белизна от плесени на дереве. Как образуется плесень

Белизна от плесени на стенах. Плесень на обоях
- Белизна от плесени на стенах. Плесень на обоях
- Белизна от плесени в ванной. Эффективность белизны
- Белизна от плесени в стиральной машине. 6 народных рецептов, как избавиться от плесени в стиральной машине своими руками
- Белизна от плесени, как разводить. Профессиональные препараты от плесени на стенах
- Убивает ли хлорка плесень. Ударим хлоркой по плесени! Обзор средств
- Белизна от плесени на дереве. Как образуется плесень
- Нужно ли смывать белизну со стен. Правила применения Белизны
Белизна от плесени на стенах. Плесень на обоях
Если на обоях появилась плесень, то стоит серьезно задуматься не только о том, как удалить ее, но и о том, почему она появилась. Скорее всего, в помещении высокий процент влажности, а в места появления грибков плохо или вообще не попадает воздух. Скорее всего, мебель в таких местах стоит вплотную к обоям, что перекрывает им доступ воздуха, а это самая благоприятная среда для размножения грибков.
Итак, первым делом нужно определить степень поражения обоев грибком. Если спор немного, и они не задели поверхность стены и плинтусов, то можно попробовать убрать их поселения и оставить обои на месте. Для этого можно воспользоваться пульверизатором, распылить раствор на пораженные участки и подождать, пока черный цвет исчезнет полностью. Далее необходимо при помощи механической чистки убрать остатки плесени.
 Плесень на обоях
Плесень на обоях
В случае если плесень глубоко поразила обои в помещении, придется провести следующие процедуры по избавлению стен от грибка. Прежде всего приготовим инструменты, которые нам для этого пригодятся — губка, шпатель, наждачная бумага, перчатки, респиратор.
Вначале нам придется полностью удалить обои со стен. При помощи шпателя очищаем участки, на которых имеется плесень. Убираем со стен остатки штукатурки. Далее нам необходимо с помощью наждачной бумаги зачистить все зараженные места. Теперь наносим Белизну на стены при помощи кисти. Оставляем просохнуть на некоторое время, а потом повторяем процедуру нанесения Белизны. Так вы будете уверены, что полностью избавились от грибка на стенах. Теперь можно клеить новые обои и следить уже за тем, чтобы и на них не образовалась плесень.
Белизна от плесени в ванной. Эффективность белизны

Аналог белизны
Белизна или попросту хлорка, как ее называют в народе, является эффективным способом борьбы с грибком в виде плесени, но только в том случае, если она не успела серьезно разрастись и поразить поверхность глубоко. Обработка хлорсодержащим раствором обеспечивает гибель микроскопических организмов. Белизна против плесени в этом случае является дезинфицирующим средством.
Единственной проблемой является то, что хлорка не проводит профилактику. Если другие средства не просто убивают грибок, но и предотвращают его появление, белизна способна только вывести уже имеющуюся плесень. Это не говорит о том, что применение белизны бесполезно. Именно с этого средства нужно начинать борьбу с грибковым налетом. В случае малой эффективности можно начинать применение более серьезных препаратов.
Следует помнить, что использование белизны от плесени на стенах может их испортить. Она обладает хорошим отбеливающим эффектом, а поэтому применять ее можно не на всякой поверхности. При необходимости сохранения отделки, лучше отдать предпочтения менее агрессивным средствам.
Белизна уже много лет используется в разных сферах, как прекрасное средство для дезинфекции. В домах и даже больницах таким раствором обрабатывают полы для уничтожения болезнетворных бактерий, даже если поверхность пола выполнена из доски. В магазинах можно встретить огромное количество отбеливающих и дезинфицирующих средств, но при этом белизна не теряет своей актуальности. К тому же она имеет весьма демократичную цену, аналог будет стоить куда дороже. Споры плесени белизна убивает непревзойденно, и такой способ применяется давно.
Важно! Обработка белизной стен от плесени должна проводиться по всем правилам техники безопасности.
Белизна от плесени в стиральной машине. 6 народных рецептов, как избавиться от плесени в стиральной машине своими руками
Плесень в стиральной машине – неприятное явление, свидетельствующее о распространении в барабане грибка. Грибок портит внешний вид техники, ухудшает работу и приводит к неприятному запаху от выстиранной одежды. Проблеме избавления от плесени в стиральной машине посвящен этот материал.
Народные способы избавиться от налета
Наряду с фунгицидными средствами бытовой химии отличные противогрибковые свойства демонстрируют вещества, применяемые в быту.
Лимонная кислота
Лимонная кислота обладает осветляющими, дезинфицирующими и дезодорирующими свойствами. С ее помощью удается избавиться не только от плесени, но и от неприятного запаха затхлости.
Кислоты понадобится много – около 200 г, это примерно 8-10 стандартных пакетиков (в зависимости от граммажа).
Пошаговая инструкция:
- Контейнер под порошок и отсек под него тщательно просушивают.
- Засыпают в лоток 200 г лимонной кислоты.
- На панели управления выбирают самый длинный режим стирки при максимальной температуре.
- Когда процесс будет завершен, сухой тканевой салфеткой протирают все внутренние поверхности устройства, особое внимание уделяя уплотнительной резинке.
- Оставляют технику проветриваться с открытой дверцей. Для ускорения высыхания можно направить на него теплую струю тепловентилятора. Это так же легко как очистить барабан стиральной машины изнутри

Совет! Метод с лимонной кислотой подходит и для профилактики появления грибка. С этой целью устраивают профилактическую стирку “вхолостую” примерно 1 раз в 6-8 месяцев.
Лимонная кислота и “Доместос”
Сантехническое средство Domestos завоевало популярность благодаря высокой эффективности в борьбе с бактериями и известковым налетом. За очищающие свойства отвечают гипохлорит натрия, анионные и неионогенные ПАВ в составе.
Как использовать:
- Гель Domestos наносят на чистящую губку и тщательно протирают все доступные внутренние детали – лучше работать обратной, жесткой стороной мочалки.
- Через 4 часа заправляют контейнер для порошка 3 столовыми ложками лимонной кислоты.
- Автомат включают на режим полоскания.
- По завершении полоскания заправляют устройство еще такой же порцией “лимонки”.
- Переключаются на режим стирки – максимальное время и температура воды.
Когда стирка будет завершена, останется протереть все детали насухо и оставить технику выветриваться. Метод хорош для избавления одновременно от плесени и известкового налета .

Важно! Работать с хлорсодержащей бытовой химией разрешается только в защитных перчатках и при открытом окне.
Отбеливатель и высокие температуры
Обычный отбеливатель, известный как “Белизна”, изготавливается на основе хлора . Хлорка знаменита своими антибактериальными свойствами, но борется она еще и с грибком.
Под действием высоких температур фунгицидные свойства хлора усиливаются.
Как проводится очистка:
- В отсек для стирального порошка заливают 1 литр “Белизны”. Если машинка малогабаритная, раствора может потребоваться меньше, с этим средством у вас отпадет вопрос.
- Устанавливают режим стирки на максимально высокие температуры – идеально около 90 °С.
- В настройках на панели выставляют функцию дополнительного полоскания.
- После старта дожидаются полчаса, затем останавливают цикл и оставляют барабан на несколько часов “отмокать”.
- По истечении отведенного времени снова запускают процесс стирки и дожидаются начала цикла полоскания.
- В процессе полоскания в отсек для моющих средств вливают 2 стакана обычного столового уксуса.
- По окончании стирки оставляют дверцу открытой до полного выветривания, а лучше протереть детали насухо.

Белизна от плесени, как разводить. Профессиональные препараты от плесени на стенах
 Часто в помещении встречается несколько видов плесени и грибка. Бывает белый налет, который возникает в результате переувлажнения грунта или как реакция на применение определенных подкормок для цветов. Зелёный вид плесени можно увидеть на пищевых продуктах, он является причиной инфекций у человека. А также грибок иногда появляется на стройматериалах. Чёрный налёт возникает на любой поверхности, досках, обоях, бетоне, краске и штукатурке. Еще налет бывает синего цвета . Он встречается на деревянных изделиях, например, паркете, раме или мебели. Другим врагом древесины считается налёт от гниения.
Часто в помещении встречается несколько видов плесени и грибка. Бывает белый налет, который возникает в результате переувлажнения грунта или как реакция на применение определенных подкормок для цветов. Зелёный вид плесени можно увидеть на пищевых продуктах, он является причиной инфекций у человека. А также грибок иногда появляется на стройматериалах. Чёрный налёт возникает на любой поверхности, досках, обоях, бетоне, краске и штукатурке. Еще налет бывает синего цвета . Он встречается на деревянных изделиях, например, паркете, раме или мебели. Другим врагом древесины считается налёт от гниения.
Причиной возникновения проблемы специалисты называют влажность , превышающую 60%. А также плесень появляется из-за некачественной гидроизоляции фундамента в частных домах, плохой вентиляции, высокой плотности пластиковых окон, при недостаточном отоплении или замерзании стен в холодную погоду.
 Бороться с грибком можно с помощью современной химии. Сейчас в бытовых магазинах можно встретить много антисептиков и других специальных средств от плесени. Некоторые растворы продаются в канистрах, другие в баллончиках. Препарат наносится после очистки налета с поверхности. Потом поверхность покрывается антисептической грунтовкой.
Бороться с грибком можно с помощью современной химии. Сейчас в бытовых магазинах можно встретить много антисептиков и других специальных средств от плесени. Некоторые растворы продаются в канистрах, другие в баллончиках. Препарат наносится после очистки налета с поверхности. Потом поверхность покрывается антисептической грунтовкой.
Лучшим средством для обработки стен от плесени можно назвать «Олимп Стоп Плесень». Это прозрачный раствор, который используется для обработки поверхностей в подвалах или квартирах. Он спасает окрашенные и оштукатуренные стены, гипсокартон, керамику, камень, дерево и кирпичные поверхности.
Топ-5 средств от грибка в квартире
Идеальный способ борьбы с грибком — это капитальный ремонт вентиляционного короба. Благодаря этому жилище будет нормально проветриваться, а плесень не заведется. Если нет времени на ремонт или в квартире всё хорошо с проветриванием и отоплением, то эффективным методом борьбы против плесени будет антисептический препарат. Специальные средства помогают избавиться от грибков на продолжительный период. Самые популярные фунгицидные растворы :
- Биосид. Средство прекрасно справляется с грибками. Производство Германия, стоимость 850 р. за 10 литров. Расход продукта осуществляется в пропорциях 100 мл на квадратный метр. Препарат используется для работ внутри здания и снаружи. Биосид разводится в соотношении 1:3. Жидкость обладает приятным запахом из-за содержащихся в ней ароматизаторов.
- Фонгифлюид Alpa. Это активный фунгицидный раствор производства России. Стоимость 560 р. за 2 литра, 1300 р. за 5 л и 3300 р. за 20 л. Формула создана на базе противодействующих и противогрибковых компонентов. Раствор нужен для нанесения на внутреннюю поверхность в квартире или доме, а также обработки снаружи помещения. Не причиняет вред цвету поверхности кафеля и лакокрасочного покрытия. Продается в готовом разведенном состоянии, поэтому его используют в соотношении 1л на 5 квадратных метров помещения. Перед использованием средства, все шершавые, рыхлые и пористые поверхности зашкуриваются, а затем выравниваются. При сильном заражении процедуру нужно повторить один или два раза. Средство не наносится при температуре ниже + 5 градусов Цельсия. Для нанесения используется кисть, валик или специальный пистолет.
- Олимп Стоп Плесень. Это агрессивный антисептик против грибков. Предназначен преимущественно для парников, погребов, подвалов и ванной комнаты. Стоимость Стоп Плесень 100 р. за 1 л или 370 р. за 5 литров. Не содержит летучих токсических элементов или хлорных соединений. Безопасен для животных и людей. Состав используется для кирпича, бетона, окрашенных и оштукатуренных стен, гипсокартона, каменных и керамических поверхностей. Его можно приобрести в строительных магазинах.
 Дали — антисептик, производитель — компания Rogneda. Стоимость препарата 570 р. за 5 л и 160 р. за 0.7 л. Средство можно приобрести в любых строительных или бытовых магазинах. Продукт наносится на следующие виды поверхностей: обои, косяки, сантехнику, окна, окрашенные и покрытые лаком поверхности, кафельную и керамическую плитку, картон или гипсокартон, древесину, штукатурку, кирпич, бетон. Дали показывает большую степень эффективности при поражении любым биологическим грибком. Это говорит об универсальности средства, оно уничтожает не только плесень и грибки, но и водоросли.
Дали — антисептик, производитель — компания Rogneda. Стоимость препарата 570 р. за 5 л и 160 р. за 0.7 л. Средство можно приобрести в любых строительных или бытовых магазинах. Продукт наносится на следующие виды поверхностей: обои, косяки, сантехнику, окна, окрашенные и покрытые лаком поверхности, кафельную и керамическую плитку, картон или гипсокартон, древесину, штукатурку, кирпич, бетон. Дали показывает большую степень эффективности при поражении любым биологическим грибком. Это говорит об универсальности средства, оно уничтожает не только плесень и грибки, но и водоросли. Неомид Bio. Производство России, выпускается в форме концентрата. Объём ёмкости с распылителем-дозатором 0.5 кг. Активным веществом является набор антибактериальных и антигрибковых биоцидов и воды. Средство наносится на нетронутую заплесневелую плоскость, через 2 часа удаляется шпателем. Срок годности не более 2 лет. Стоимость состава 480 р.
Неомид Bio. Производство России, выпускается в форме концентрата. Объём ёмкости с распылителем-дозатором 0.5 кг. Активным веществом является набор антибактериальных и антигрибковых биоцидов и воды. Средство наносится на нетронутую заплесневелую плоскость, через 2 часа удаляется шпателем. Срок годности не более 2 лет. Стоимость состава 480 р.Убивает ли хлорка плесень. Ударим хлоркой по плесени! Обзор средств
Писал очередную заметку в канал , по поводу средств, которые пригодны для уничтожения вируса (не буду напоминать какого, все и так в курсе) на поверхностях в жилых помещениях. Поверхности - это в т.ч. полы и мебель. Многие читатели часто спрашивают "чем вирулицидным можно протирать поверхности в доме/квартире". Ситуация осложняется тем, что многие производители не указывают на этикетках своей продукции ни концентраций действующих веществ, ни рекомендаций к применению, поэтому ниже я сделал подборку некоторых компонентов (с указанием их зарубежных синонимов, чтобы проще было найти на этикетке), на которые можно ориентироваться при покупке. В сегодняшней заметке - одни из самых действенных дезинфектантов, вещества-прекурсоры активного хлора. При протирании эти вещества способны не только дезактивировать вирусы (а также бактерии и т.п.), но иногда даже уничтожать плесень и грибок (что немаловажно в "мирное время").

Итак, их величество хлорпроизводные, или "прекурсоры активного хлора":
1) Дихлоризоцианурат натрия (натриевая соль дихлоризоциануровой кислоты ДХЦК/Dichloroisocyanuric acid sodium salt/dichlor/dichloro-s-triazinetrione/troclosene). Препарат выпускается в виде порошка, при разведении растворы сохраняют активность в течении 3-5 суток. Препарат обладает вирулицидным действием в концентрациях от 0,03% (экспозиция 60 минут) и выше. С ростом концентрации время обработки сокращается
2) Дихлорантин (1,3-дихлор-5,5-диметилгидантоин/1,3-Dichloro-5,5-dimethyl-2,4-imidazolidinedione, DCDMH) органическое соединение, производное гетероциклического соединения диметилгидантоина. Препарат выпускается в виде порошка, при разведении растворы сохраняют активность в течении 10-15 суток. Препарат обладает вирулицидным действием в концентрациях не ниже 0,125% (экспозиция 60 минут). С ростом концентрации экспозиция уменьшается.
3) Гипохлорит натрия (Sodium hypochlorite). Препарат обладает вирулицидной активностью в концентрациях от 1 % (экспозиция 30 минут). Для уничтожения плесени необходима концентрация не менее 10% и двукратное протирание или орошение с интервалом 30 минут.
4) Гипохлорит кальция (хлорная известь/"хлорка"/Calcium hypochlorite). Необходима концентрация раствора не менее 0,5% и экспозиция 30 минут
5) Трихлоризоциануровая кислота (ТХЦК/Trichloroisocyanuric acid). Препарат выпускается в виде порошка, при разведении растворы сохраняют активность в течении суток. Вирулицидная активность проявляется в концентрациях от 0,1% с экспозицией 40 минут.

Белизна от плесени на дереве. Как образуется плесень
Плесень является одним из видов грибкового поражения древесины. Грибы образуются на поверхности при высокой влажности и (или) недостаточной вентиляции помещения. Возникнув на небольшом участке, плесень стремительно распространяется, завоевывая большую площадь. При соприкосновении деревянных конструкций или деталей, грибок быстро переходит на здоровую древесину.
Теплая и сырая погода – оптимальная среда для образования плесени. Примечательно, что даже окрашенная или покрытая лаком древесина может поражаться ей. Правда, в этом случае разрушения дерева будут минимальны, если убрать споры грибов вовремя.
Поражение плесенью происходит на всех стадиях роста дерева и его использования. При наличии благоприятных условий грибы образуются на коре или под ней. Обычно поражение начинается с северной стороны, где освещенность солнцем минимальна. В густых лесах, где солнце недостаточно освещает стволы деревьев, поражения могут занимать значительную часть ствола. Вот почему сразу после спиливания дерева рекомендуется производить очистку его от коры.
образуются на коре или под ней. Обычно поражение начинается с северной стороны, где освещенность солнцем минимальна. В густых лесах, где солнце недостаточно освещает стволы деревьев, поражения могут занимать значительную часть ствола. Вот почему сразу после спиливания дерева рекомендуется производить очистку его от коры.
На стволах свежеспиленных деревьев также могут образовываться колонии грибов. Даже при отсутствии плесени на стволе, после распиловки его на сортовые материалы, грибок может поражать их, если условия сушки были неудовлетворительные.
В строительстве причинами появления плесени могут стать неправильная пароизоляция, отсутствие или нарушение гидроизоляции, отсутствие вентиляционных зазоров при контакте материалов с разной плотностью.
В домашних условиях плесень охотно поражает любые деревянные изделия, хранящиеся в теплой влажной среде. Очень часто, особенно в деревенских домах без вентиляции, можно увидеть заплесневевшую деревянную посуду или покрытые грибком полки шкафов. Это происходит из-за недостаточного проветривания внутреннего объема, в котором хранятся изделия.

Нужно ли смывать белизну со стен. Правила применения Белизны
Объявляя войну плесени, необходимо в первую очередь установить причину ее появления. Если просто избавляться от следов паразитирования грибка путем регулярного проведения уборки, нужного результата это не даст. Даже самые эффективные средства, чье действие направлено против активного размножения специфического микроорганизма, носят временный характер. Только после того, как станет понятно, из-за чего на стенах появляются разноцветные колонии, и будут предприняты соответствующие превентивные меры, можно приступать к устранению следов плесени и результатов ее жизнедеятельности.
В случае, если колонии грибка покрывают только небольшие участки и еще не успели повлиять на качество штукатурки, обоев и другого сырья, действуем по следующей схеме:
- Наносим Белизну непосредственно на пораженные участки. Это можно сделать с помощью кисточки, губки, пульверизатора. Предварительно разводить состав не нужно, концентрированный продукт даст лучший эффект.
Совет: Если приходится иметь дело с цветными обоями, то лучше сначала проверить, как Белизна повлияет на их цвет. Вообще, хлорные отбеливатели лучше применять для обработки штукатурки, плитки, деревянных и каменных поверхностей. Для ткани и бумаги лучше подобрать что-то менее агрессивное.
- Оставляем обработанные на стенах участки самостоятельно высыхать, не используя фен или другие источники искусственного тепла для ускорения процесса.
- По мере высыхания хлорки пятна плесени будут светлеть и потом совсем исчезнут, но это не значит, что борьба против колоний грибка завершена.
- Далее берем плотную щетку и начинаем проводить механическую обработку пораженных участков, пока не удастся избавиться от малейших следов паразита.
обладает резким запахом и агрессивна по отношению к окружающим предметам. Поэтому процедуру удаления плесени на стенах, потолке и предметах мебели рекомендуется проводить в условиях хорошей вентиляции и только в резиновых перчатках.